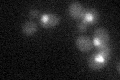
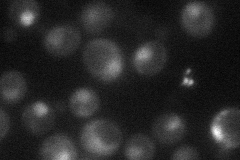
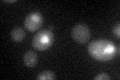

View description
Transcriptional co-repressor of MBF (MCB binding factor)-regulated gene expression; Nrm1p associates stably with promoters via MBF to repress transcription upon exit from G1 phase
Localization:
Intensity:
Fold change:
Significance:
-
C’ GFP library in SD
nucleus19.65 -
N' NOP1pr-GFP in SD
nucleus31.4935 -
N' TEF2pr-mCherry in SD

below threshold5.26394 -
N' NATIVEpr-GFP in SD

nucleus24.3877 -
N' TEF2pr-VC and Cyto-VN in SD

#N/A0 -
C’ GFP library in SD+DTT
nucleus20.061.02No -
C’ GFP library in SD+H2O2

nucleus17.870.9No -
C’ GFP library in Starvation Media

nucleus15.080.76No -
C’ GFP library on the background of Pup2-DaMP

N/A -
C’ GFP library on the background of CCT mutant

N/A0N/AYes
